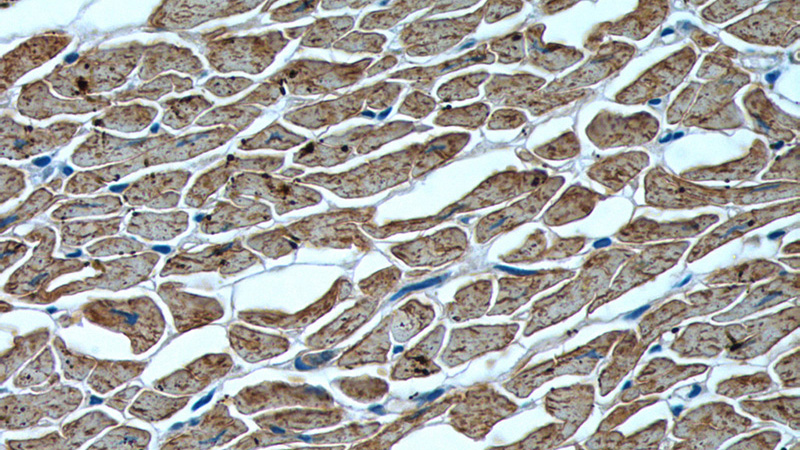
Immunohistochemistry of paraffin-embedded human heart tissue slide using Catalog No:112995(MYL2 Antibody) at dilution of 1:200 (under 40x lens)

-
Product Name
Myosin Light Chain 2 antibody
- Documents
-
Description
Myosin Light Chain 2 Rabbit Polyclonal antibody. Positive IP detected in mouse heart tissue. Positive WB detected in mouse heart tissue, rat heart tissue. Positive IHC detected in human heart tissue. Observed molecular weight by Western-blot: 19 kDa
-
Tested applications
ELISA, WB, IP, IHC
-
Species reactivity
Human,Mouse,Rat,Zebrafish; other species not tested.
-
Alternative names
CMH10 antibody; MLC 2 antibody; MLC 2v antibody; MLC2 antibody; MLC2V antibody; MYL2 antibody; Myosin Light Chain 2 antibody
- Immunogen
-
Isotype
Rabbit IgG
-
Preparation
This antibody was obtained by immunization of Myosin Light Chain 2 recombinant protein (Accession Number: NM_000432). Purification method: Antigen affinity purified.
-
Clonality
Polyclonal
-
Formulation
PBS with 0.1% sodium azide and 50% glycerol pH 7.3.
-
Storage instructions
Store at -20℃. DO NOT ALIQUOT
-
Applications
Recommended Dilution:
WB: 1:500-1:5000
IP: 1:200-1:2000
IHC: 1:50-1:500
-
Validations

mouse heart tissue were subjected to SDS PAGE followed by western blot with Catalog No:112995(MYL2 antibody) at dilution of 1:1000

IP Result of anti-MYL2 (IP:Catalog No:112995, 3ug; Detection:Catalog No:112995 1:500) with mouse heart tissue lysate 6000ug.

Immunohistochemistry of paraffin-embedded human heart tissue slide using Catalog No:112995(MYL2 Antibody) at dilution of 1:200 (under 10x lens)
Immunohistochemistry of paraffin-embedded human heart tissue slide using Catalog No:112995(MYL2 Antibody) at dilution of 1:200 (under 40x lens)
-
Background
MYL2, also named as MLC-2v and MLC-2, is ventricular/cardiac muscle isoform. Defects in MYL2 are the cause of cardiomyopathy familial hypertrophic type 10 (CMH10). Defects in MYL2 are the cause of cardiomyopathy familial hypertrophic with mid-left ventricular chamber type 2 (MVC2). MYL2 has been widely used as a marker of mature ventricular cardiomyocytes.
-
References
- Zhang J, Wilson GF, Soerens AG. Functional cardiomyocytes derived from human induced pluripotent stem cells. Circulation research. 104(4):e30-41. 2009.
- Xu Y, Wang H, Zhou J. Zebrafish Nanos interacts with and regulates the phosphorylation of Mylz2. Biochimie. 92(12):1812-7. 2010.
- Zhang Q, Jiang J, Han P. Direct differentiation of atrial and ventricular myocytes from human embryonic stem cells by alternating retinoid signals. Cell research. 21(4):579-87. 2011.
- Xi L, Zhu SG, Hobbs DC, Kukreja RC. Identification of protein targets underlying dietary nitrate-induced protection against doxorubicin cardiotoxicity. Journal of cellular and molecular medicine. 15(11):2512-24. 2011.
- Lee P, Klos M, Bollensdorff C. Simultaneous voltage and calcium mapping of genetically purified human induced pluripotent stem cell-derived cardiac myocyte monolayers. Circulation research. 110(12):1556-63. 2012.
- Koka S, Xi L, Kukreja RC. Chronic treatment with long acting phosphodiesterase-5 inhibitor tadalafil alters proteomic changes associated with cytoskeletal rearrangement and redox regulation in Type 2 diabetic hearts. Basic research in cardiology. 107(2):249. 2012.
- Minami I, Yamada K, Otsuji TG. A small molecule that promotes cardiac differentiation of human pluripotent stem cells under defined, cytokine- and xeno-free conditions. Cell reports. 2(5):1448-60. 2012.
- Lian X, Hsiao C, Wilson G. Robust cardiomyocyte differentiation from human pluripotent stem cells via temporal modulation of canonical Wnt signaling. Proceedings of the National Academy of Sciences of the United States of America. 109(27):E1848-57. 2012.
Related Products / Services
Please note: All products are "FOR RESEARCH USE ONLY AND ARE NOT INTENDED FOR DIAGNOSTIC OR THERAPEUTIC USE"
